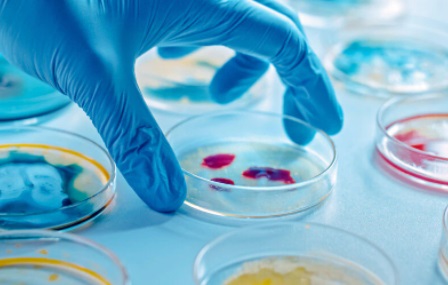

Biotecnología, la novedosa carrera de la UBA que puede estudiarse en 4 facultades
- 30 de enero de 2026
- Posted by: Administrador
- Categoría: Noticias

Este año, la Universidad de Buenos Aires (UBA) suma una nueva carrera
a su oferta académica. Es la licenciatura en Biotecnología que, además,
cuenta con una característica única, ya que se podrá estudiar en cuatro
facultades diferentes: Farmacia y Bioquímica (FFyB), Ciencias Exactas y
Naturales (FCEyN), Agronomía (Fauba) y Ciencias Veterinarias (FVET).
Las primeras inscripciones al Ciclo Básico Común (CBC), realizadas en
noviembre, dejaron en evidencia el entusiasmo que generó, aunque todavía
los números no se hicieron oficiales.
“Creemos que será muy demandada. Biotecnología no existía en la UBA y
el interés del que tenemos indicios demuestra que era un nicho para
cubrir, una falencia que la universidad no llenaba”, le dijo a la Agencia CyTA-Leloir
el doctor en matemática Guillermo Durán, decano de la FCEyN. “Es una
licenciatura de 4 años y medio, con 3.300 horas de carga horaria: un año
de CBC, tres de ciclo troncal y medio de orientación”, añadió Durán. Y
especificó que en este último tramo los alumnos podrán elegir entre
cuatro especializaciones, una por cada facultad interviniente. “Algo
completamente novedoso”, celebró.
En la FCEyN se podrá cursar la especialización de “Biotecnología y
Desarrollo Sostenible”, que ofrecerá una formación integral orientada al
diseño y la aplicación de soluciones innovadoras con enfoque en la
sostenibilidad tanto en procesos productivos como en estrategias de
gestión ambiental; la FFyB brindará la orientación “Biotecnología en
Salud Humana”; en la FVET se podrá optar por “Biotecnología en Salud y
Producción Animal”; mientras que en la Fauba se dictará “Biotecnología
Vegetal”, que aportará preparación específica para el mejoramiento
genético de las plantas de interés agronómico con un enfoque en
agricultura sustentable.
Para obtener la licenciatura, los estudiantes deberán realizar una
“Práctica Profesional Supervisada” de 300 horas asociada a la
orientación elegida o bien escribir una tesis de grado. Otra novedad es
que, al promediar la carrera, se podrá acceder a un título intermedio de
Bachiller Universitario en Biotecnología.
“Los biotecnólogos desarrollan combustibles, diseñan tecnologías de
biorremediación (transformación de tóxicos en sustancias menos nocivas),
trabajan en nanotecnología y lideran proyectos científicos y
productivos que mejoran la vida de las personas y cuidan el ambiente”,
especifica la cuenta de Instagram de la FFyB.
Necesidad estratégica
El campo de la biotecnología es uno de los que experimentan mayor expansión en el mundo: la consultora Precedence Research estima que el mercado global se triplicará en los próximos ocho años,
pasando de 1,77 billones de dólares anuales en 2025 a unos 5,71
billones de dólares para 2034. Este crecimiento, asegura, ocurrirá de la
mano del incremento de las aplicaciones agrícolas, el aumento de las
enfermedades crónicas y la fuerte preferencia por los productos
biológicos, que permiten tratamientos y fármacos personalizados.
“Hoy, la carrera de Biología tiene una orientación hacia la
biotecnología, algo que también ocurre con la carrera de Bioquímica”,
reconoció Durán. “Es que el campo de la biotecnología, es decir, el uso
tecnológico de procesos biológicos es cada vez más amplio y la
utilización de las herramientas que brinda tiene innumerables
aplicaciones tanto en salud animal y humana, como en el agro y el medio
ambiente”.
Si bien la carrera de Biología con especialización en Biotecnología y
la nueva Licenciatura en Biotecnología comparten muchos saberes, la
página web de la FCEyN aclara que apuntan a formar distintos perfiles de
egresados: “El/la Lic. en Biotecnología estará capacitado/a para
planificar, ejecutar y supervisar procesos biotecnológicos en
laboratorios, industrias y plantas piloto. Tendrá una sólida formación
científica y técnica que le permitirá intervenir en todas las etapas del
desarrollo de productos biotecnológicos, garantizando calidad y
sustentabilidad. Además, podrá participar en auditorías, asesoramientos,
regulaciones y transferencia tecnológica”, detalla.
La inscripción al Ciclo Básico Común (CBC)
–cuya primera llamada fue en noviembre de 2025– será desde el 2 hasta
el 18 de febrero. Además de las dos asignaturas obligatorias
(Introducción al Pensamiento Científico e Introducción al Conocimiento
de la Sociedad y el Estado), los ingresantes a la nueva carrera deberán
aprobar Matemática, Biología, Física y Química. Para consultar el plan
de estudios se puede hacer click acá.
La primera universidad pública en contar con una carrera de
Biotecnología en el país y en América Latina fue la de Rosario (UNR),
que lanzó la licenciatura en 1989, en la Facultad de Ciencias
Bioquímicas y Farmacéuticas. En 1994, Mario Feldman se convirtió en el
primer Licenciado en Biotecnología y luego realizó su doctorado en la
Fundación Instituto Leloir (FIL), donde se especializó en glicobiología.
Hoy Feldman dirige su propio laboratorio en la Universidad de
Washington en Saint Louis, Estados Unidos. En ese país también fundó
Omniose, una empresa biotecnológica que, por medio de una novedosa
plataforma propia, busca desarrollar vacunas innovadoras contra
bacterias que representan serias amenazadas para la salud.
En la actualidad, en Argentina se puede estudiar Biotecnología en
diversas universidades públicas y privadas, como las universidades
nacionales de San Martín (UNSAM), Hurlingham (UNAHUR), Quilmes (UNQ),
Moreno (UNM) y Tucumán (UNT), entre otras; y la Universidad Argentina de
la Empresa (UADE) y la Universidad Católica Argentina (UCA). Para la
UBA era uno de los grandes temas pendientes.
“Es un paso positivo y muy importante que la UBA dicte esta
licenciatura y forme biotecnólogos. Es la universidad más grande del
país, con una fuerte y larga tradición de investigación en ciencias
biológicas”, celebró Alberto Díaz, exdirector de la carrera de
Biotecnología de la UNQ. “Espero que la formación esté orientada hacia
la producción y la industria”, añadió el también exdirector del Centro
de Biotecnología Industrial del INTI, quien enfatizó la necesidad de
estimular el vínculo “con los muy importantes centros de investigación
que hay en la Ciudad de Buenos Aires, como la ANLIS, la Fundación
Instituto Leloir, ciertos hospitales y también con las PYMES”.
